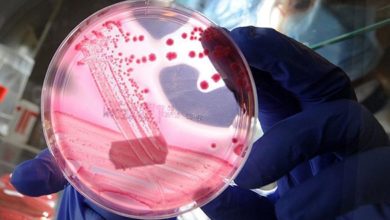

Dr. Serdar SAVAŞ
-
Genel Cerrahi
Her 3 kanser vakasından 2’sini önlemek mümkün
Ülkemizde ölümlerin ikinci büyük nedeni olan kanserlerden genlerimize uygun yaşayarak korunmak mümkün. Genlerden yola çıkılarak hazırlanan koruyucu tıp uygulamaları ile…
Devamını Oku » -
Genel Cerrahi
Her 3 kanser vakasından 2’sini önlemek mümkün
Ülkemizde ölümlerin ikinci büyük nedeni olan kanserlerden genlerimize uygun yaşayarak korunmak mümkün. Genlerden yola çıkılarak hazırlanan koruyucu tıp uygulamaları ile…
Devamını Oku » -
Kanser & Onkoloji
Her 3 kanser vakasından 2’sini önlemek mümkün
Ülkemizde ölümlerin ikinci büyük nedeni olan kanserlerden genlerimize uygun yaşayarak korunmak mümkün. Genlerden yola çıkılarak hazırlanan koruyucu tıp uygulamaları ile…
Devamını Oku » -
Genetik Rahatsızlıklar
Her 3 kanser vakasından 2’sini önlemek mümkün
Ülkemizde ölümlerin ikinci büyük nedeni olan kanserlerden genlerimize uygun yaşayarak korunmak mümkün. Genlerden yola çıkılarak hazırlanan koruyucu tıp uygulamaları ile…
Devamını Oku »